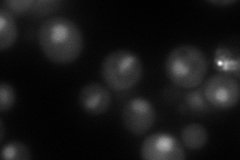
YMR033W
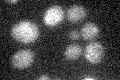
YMR033W

View description
Component of both the SWI/SNF and RSC chromatin remodeling complexes; actin-related protein involved in transcriptional regulation
Localization:
Intensity:
Fold change:
Significance:
-
C’ GFP library in SD

below threshold15.94 -
N' NOP1pr-GFP in SD

nucleus93.3945 -
N' TEF2pr-mCherry in SD
nucleus99.7581 -
N' NATIVEpr-GFP in SD

nucleus39.219 -
N' TEF2pr-VC and Cyto-VN in SD

nucleus44.1803 -
C’ GFP library in SD+DTT

cytosol19.071.19No -
C’ GFP library in SD+H2O2

cytosol17.211.07No -
C’ GFP library in Starvation Media
cytosol15.941No -
C’ GFP library on the background of Pup2-DaMP

below threshold -
C’ GFP library on the background of CCT mutant

below threshold17.04351.06895No
